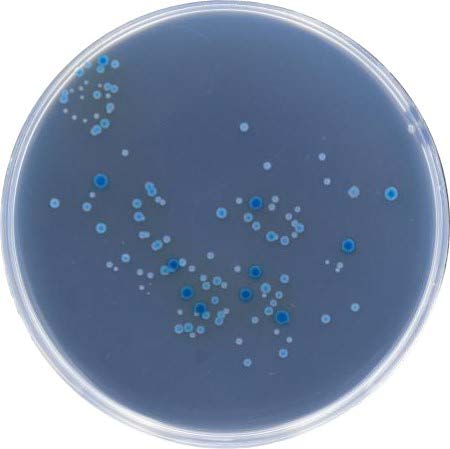

显色培养基
利用微生物自身代谢产生的酶与相应显色底物的特异性反应使菌落呈现鲜亮的色彩,这些相应的显色底物是由产色基团和微生物部分可代谢物质组成,在特异性酶作用下,游离出产色基团显示一定颜色,从而通过直接观察菌落颜色即可对菌种作出鉴定。利用显色培养基进行微生物的筛选分离,其反应的灵敏度和特异性大大优于传统培养基。
特点
· 简便:大多数无需高压灭菌即可使用
· 特异:目标菌落色泽鲜艳,易于辨识
· 可靠:经大量分离株验证,符合率高
· 快速:最快检测时间为24h
· 节省:大批量样本的处理和检测,可减少补充生化试验的时间和费用
三大优势
· 精选优质原材料:欧洲进口核心原材料,质量稳定,批间差小,性能卓越和费用
· 严格的质量控制:从原料到最终产品实行全程严格监控,做到质量溯源,确保成品批间质量稳定
· 国际高品质显色培养基:高灵敏度, 高特异性,菌落色泽鲜艳,易于辨识

- 单核细胞增生李斯特氏菌ATCC19115

- 英诺克李斯特氏菌ATCC33090

- 副溶血性弧菌 ATCC17802

- 溶藻弧菌 ATCC33787
- 阪崎肠杆菌ATCC29544

- 普通变形杆菌CMCC(B)49027

- 白色念珠菌CMCC98001

- 光滑念珠菌ATCC15126
订购信息
| 产品编号 |
产品说明 |
规格 |
| GF1106 |
沙门氏菌显色培养基(SA) Salmonella Chromogenic Ag |
1000mL/ 瓶 |
| GF1003 |
李斯特氏菌显色培养基 Listera Chromogenic Medium |
1000mL/ 瓶 |
| GF1050 |
阪崎肠杆菌显色培养基(DFI 琼脂) |
1000mL/ 瓶 |
| GF1088 |
志贺氏菌显色培养基 Shigella Chromogenic Agar |
1000mL/ 瓶 |
| GF1037 |
大肠埃希氏菌 0157 显色培养 Escherichia coli 0157 chromogenic medium |
1000mL/ 瓶 |
| GF1090 |
弧菌显色培养基(VA)Vibrio Chromogenic Agar |
1000mL/ 瓶 |
| GF1199 |
大肠菌群大肠杆菌(ECC) 显色培养基 |
1000mL/ 瓶 |
| GF1200 |
大肠杆菌显色培养基 |
1000mL/ 瓶 |
| GF1208 |
大肠菌群显色培养基 |
1000mL/ 瓶 |
| PB1106 |
沙门氏菌显色培养基平板 |
10 皿/ 包x2 |
| PB1003 |
李斯特氏菌显色培养基平板 |
10 皿/ 包x2 |
| PB1050 |
阪崎肠杆菌显色培养基平板 |
10 皿/ 包x2 |
| PB1088 |
志贺氏菌显色平板 |
10 皿/ 包x2 |
| PB1037 |
大肠埃希氏菌 0157 显色培养基平板 |
10 皿/ 包x2 |
| PB1090 |
弧菌显色培养基平板 |
10 皿/ 包x2 |







